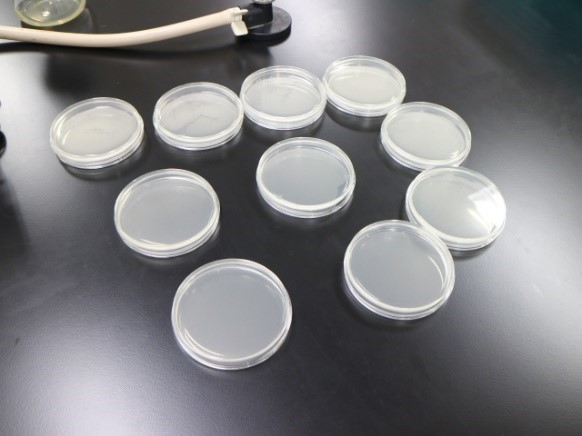

こんにちは。実験担当助手の浦です。
先週より、実験実習の対面授業が始まっています。今年度初めての対面ということで、我々教職員も少し緊張していますが、何より学生の皆さんと授業が出来ることに喜びを感じています。
久しぶりに再会を果たした学生さん同士も、とっても嬉しそう!
さてさて、少し授業を覗いてみましょう♪
こちらは、『食品衛生学実験』の様子です。
写真は細菌を観察する為の準備をしているところです。みなさん久しぶりの授業に少し戸惑いながらも、一生懸命実験に取り組んでいましたよ。
一度に受け入れる人数を減らしたり、マスク着用の徹底、換気、消毒を行う等、大学でも対策を行いながら授業を進めています。